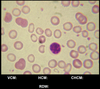
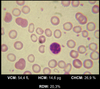
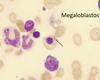
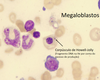
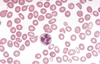
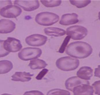
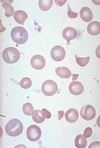
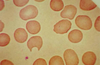
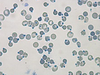
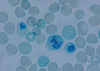
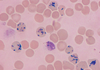

Hematologia 2º bim Flashcards
(27 cards)
1
Q

A
Talassemias
Pesquisa de HbB (Azul de Cresil Brilhante)
2
Q

A
G6PDH
Corpos de Heinz
3
Q

A
Beta Talassemia
Corpos de Heinzs
4
Q

A
Talassemias
Microcitose
5
Q

A
Talassemias
Microcitose
6
Q

A
Talassemias
Pontilhado Basófilo (RNA)
7
Q

A
Talassemias
Resposta Exagerada à Hemólise (Eritroblastos)
8
Q
A
9
Q

A

10
Q

A
Megaloblastos
11
Q

A
Megaloblastos
12
Q
A
13
Q

A
Megaloblastos
14
Q

A
Megaloblastos
15
Q

A
Megaloblastos
16
Q
A
Megaloblastos
17
Q

A

18
Q

A
Anemia Falciforme
19
Q

A
Anemia Falciforme
20
Q
A
Hemoglobinopatia C
21
Q
A
G6PDH
Esquizócitos (He em Elmo)
22
Q

A
G6PDH
Esquizócitos (He em Elmo)
23
Q
A
G6PDH
Hemiestroma
24
Q
A
G6PDH
Heinz
25
G6PDH
Reticulócitos
26
G6PDH
Reticulócitos
27

PK
Hes Crenadas